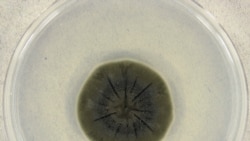

Многие уже хотят забыть все, что случилось в 2020 году, однако под грудой неприятных заголовков и тревожных новостей затерялось и несколько хороших. Радио Свободная Европа/Радио Свобода рассказывает о главных из них.
Новый источник энергии: термоядерный синтез изменит мир
Мечты ученых о чистых термоядерных реакторах, способных питать города, стали чуть ближе к реальности в августе, когда президент Франции Эммануэль Макрон объявил о начале сборки Международного термоядерного экспериментального реактора (ИТЭР).
Управляемый ядерный синтез может стать революцией в мировой энергетике. В отличие от реакции деления ядра, когда атомы расщепляются, выделяя энергию, которая способна сровнять с землей Хиросиму, при ядерном слиянии нагретые частицы в вакууме сталкиваются, объединяясь в более крупный атом. Получаемая таким образом энергия не связана с выбросами вредных веществ и при этом практически бесконечна. Топлива для такой реакции требуется немного, и часть его можно добывать из морской воды.
О проекте ИТЭР впервые заговорил советский лидер Михаил Горбачев в беседе с президентом США Рональдом Рейганом в 1985 году. С тех пор к нему присоединились другие страны, были инвестированы колоссальные суммы. Первый тест реактора ИТЭР намечен на 2025 год.
Неспешное развитие проекта подтолкнуло другие организации поэкспериментировать с камерами термоядерного синтеза, теоретическое обоснование которого было предложено советскими учеными еще в 1950-е. Так или иначе, в случае успеха проблема доступности энергии для человечества может быть решена в обозримом будущем.
Чернобыльский грибок спасает от космической радиации
В августе ученые из Стэнфорда и Университета Северной Каролины опубликовали статью о том, что грибок, выросший в Чернобыле, может помочь космонавтам высадиться на Марс и даже жить там в безопасности.
Эти данные появились после того, как побывавшие на Чернобыльской АЭС ученые обратили внимание на неприглядный черный грибок, разросшийся внутри облученной зоны.
Дальнейшие исследования показали, что грибок-экстремал способен перерабатывать радиацию в энергию, что позволяет ему процветать на АЭС. Подобная тяга к радиации навела ученых на мысль отправить образец этого грибка на Международную космическую станцию.
Одним из главных препятствий для высадки человека на Марс является космическая радиация, с которой космонавты сталкиваются за пределами атмосферы Земли. Поэтому НАСА была крайне заинтересована в том, чтобы посмотреть, как радиотрофный гриб поведет себя в космосе.
Внутри МКС над датчиком радиации подготовили "лужайку" для Cladosporium sphaerospermum толщиной 1,7 мм. Грибок поглотил 2% радиации на МКС. Этот результат может показаться скромным, однако статья произвела фурор в научных кругах, потому что там делается вывод, что если увеличить толщину грибкового слоя до 21 сантиметра, он практически полностью защитит космонавтов от радиации.
Особенно многообещающа эта находка в связи с тем, что такую плесень можно вырастить на Марсе или на борту космического корабля, направляющегося на эту планету.
"Древесное цунами" в Пакистане держит рабочих на плаву
Около 60 000 пакистанцев, оставшихся без работы и часто без средств к существованию из-за карантинных мер, нашли себя на новом поприще – высадке деревьев.
Инициатива по восстановлению пакистанских лесов и высадке 10 миллиардов деревьев с 2018 по 2023 год заглохла с началом пандемии, как и вся экономика страны. Однако решение властей приостановить высадку деревьев вскоре было отменено, и отправленные в неоплачиваемый отпуск рабочие снова принялись за дело.
Рабочие, которым грозила голодная смерть, теперь каждый день получают небольшую зарплату в 500 рупий (около трех долларов). Один из озеленителей рассказал корреспонденту агентства Reuters: "Из-за коронавируса города закрылись, и работы не стало. Многие из нас потеряли возможность заработать себе на жизнь". Инициатива по высадке деревьев, по его словам, означает, что "все мы снова можем получать ежедневную зарплату и прокормить наши семьи".
Окрашенная ветряная мельница оказалась значительно безопаснее для птиц
Норвежские ученые нашли простой способ предотвратить смерть многих тысяч птиц, погибающих каждый год от лопастей ветряных мельниц.
В июле была опубликована статья, основанная на многолетних исследованиях на ветряной ферме в Смёле в Норвегии. Там говорится, что число погибших птиц резко сократилось после покраски в черный одной из лопастей на некоторых ветрогенераторах.
Смерть птиц – один из самых эмоциональных аргументов против ветроэнергетики. Птицы особенно беззащитны перед быстро крутящейся мельницей, которая в туманные дни неотличима для них от окружающего неба. На ферме в Смёле до начала исследований погибло несколько орланов-белохвостов.
Используя служебных собак, чтобы найти скелеты птиц, ученые установили, что после покраски лопастей количество погибших птиц сократилось на 70%. Очевидно, краска делает их более заметными для пернатых, и те облетают опасную зону.
Еще предстоит установить, не являются ли эти результаты специфичными для конкретной местности и видов птиц. Ветряные фермы в ЮАР и Нидерландах готовятся повторить этот эксперимент.
Вьетнам успешно борется с незаконной торговлей дикими животными
Уже после начала пандемии коронавируса, источник которой, по некоторым данным, происходит с печально известного рынка диких животных в Китае, Вьетнам начал активную борьбу с незаконной торговлей животными. Ранее Вьетнам считался одним из основных перевалочных пунктов такой торговли.
В июле мировые новостные агентства сообщили как сенсацию, что Вьетнам вводит запрет на торговлю дикими животными, чтобы снизить риск вспышек новых заболеваний в будущем. Эксперты внутри страны говорят, что это не так: правительство просто призвало более активно исполнять уже действующие законы. Однако на фоне пандемии этот призыв не кажется пустой риторикой.
По данным экологов, за последние два года во Вьетнаме задержания браконьеров выросли на 44%, а в 2020 году 97% задержанных контрабандистов были арестованы. Наказания за торговлю дикими животными также значительно ужесточили.
Оригинальная версия материала была впервые опубликована на английском языке на сайте Радио Свобода/Радио Свободная Европа